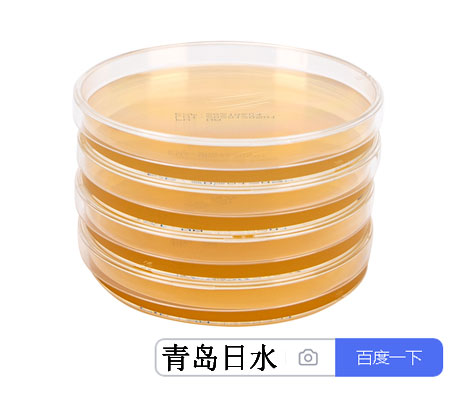

| 提交询价信息 |
| 发布紧急求购 |
价格:电议
所在地:山东 青岛市
型号:12427-
更新时间:2024-09-13
浏览次数:740
公司地址:山东省青岛市黄岛区黄河西路86号
![]()
孙先生(先生) 销售
青岛日水生物详见网站
免责声明:以上所展示的[12427- 一次性预灌装培养基无菌平皿tsa山东日水]信息由会员[青岛日水生物技术有限公司]自行提供,内容的真实性、准确性和合法性由发布会员负责。